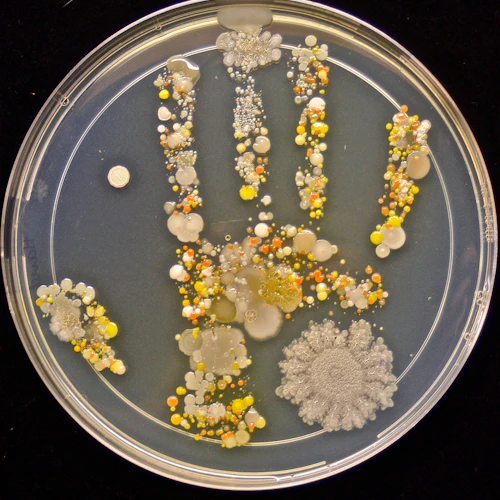

MUJERES EN CABRILLO
Las mujeres han desempeñado un papel fundamental en el éxito de Cabrillo Community College desde su fundación en 1959, y la universidad es un orgulloso miembro institucional del California Community Colleges Womens Caucus.
El California Community Colleges Women's Caucus (CCCWC) tiene como objetivo unificar y apoyar a las mujeres de los Community Colleges de California, mientras identifica oportunidades únicas para fortalecer el éxito de los estudiantes, profesores y empleados en nuestro sistema. Siguiendo el liderazgo del CCCWC, Cabrillo se compromete a:
* Reconocer las contribuciones de las mujeres
* Apoyar el desarrollo de liderazgo
* Promover oportunidades profesionales y equidad salarial
* Ampliar la cantera para los líderes del mañana
Esta página está dedicada a celebrar a las mujeres por sus contribuciones pasadas, presentes y futuras a nuestra universidad. En todas las disciplinas, y entre todo el personal docente, administrativo y estudiantil, el empoderamiento de las mujeres es una base integral para el éxito de todos.


¿Cómo puedo nominar a alguien?